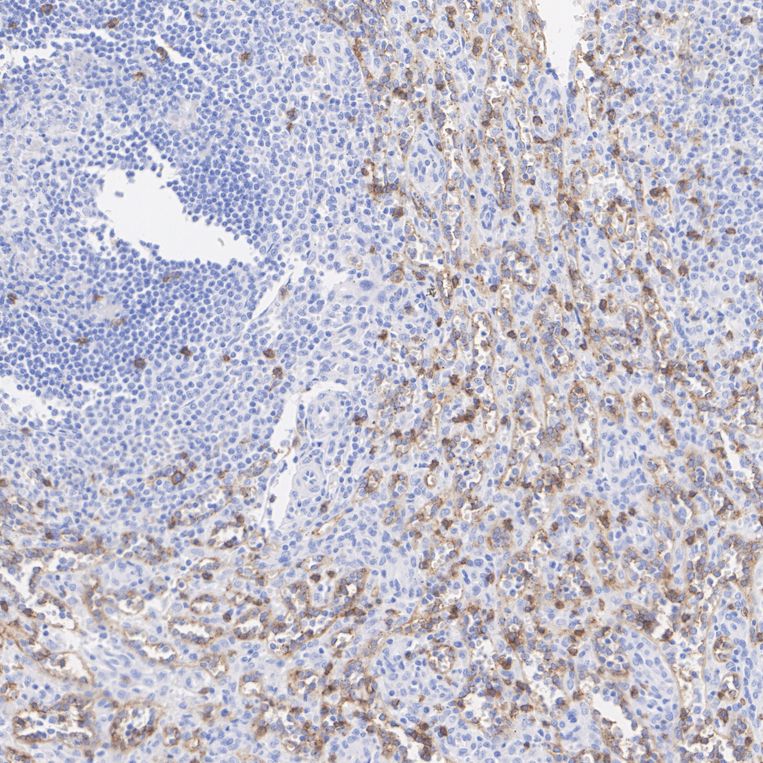

Rmb: 618 特惠 1500
Catalog# HA724105
CD8 alpha Recombinant Rabbit Monoclonal Antibody [PSH19-81]
Application
-
WB
-
IHC-P
-
IF-Tissue
-
FC
-
mIHC
Reactivity
-
Human
-
Rat
BSA and Azide free
-
HA751735
不含抗保成分
Conjugation
-
unconjugated

浙公网安备 33019202000643号
浙公网安备 33019202000643号